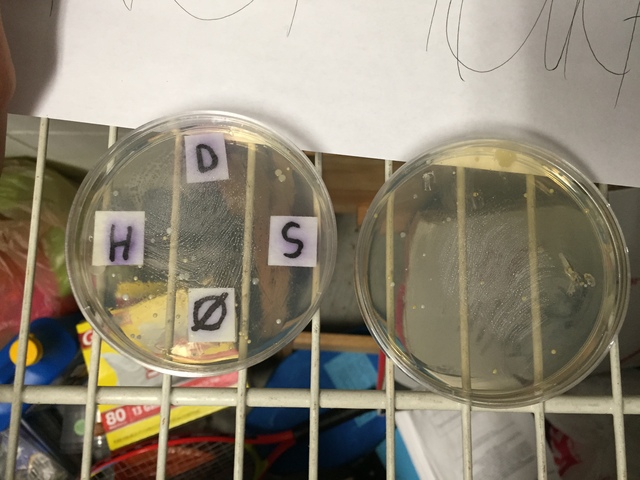
Petri Dish Day 4
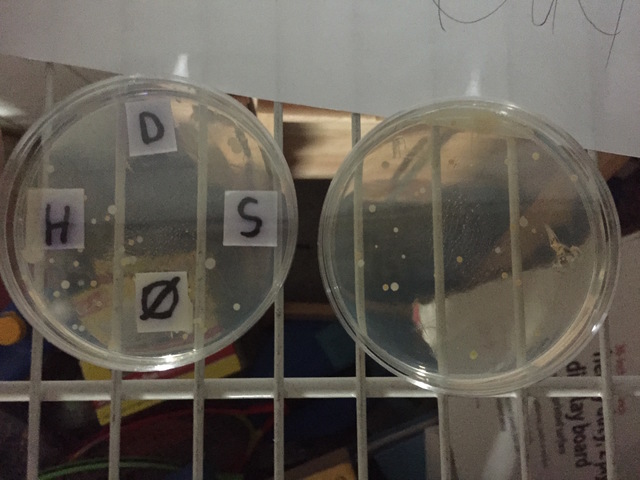
Petri Dish Day 5
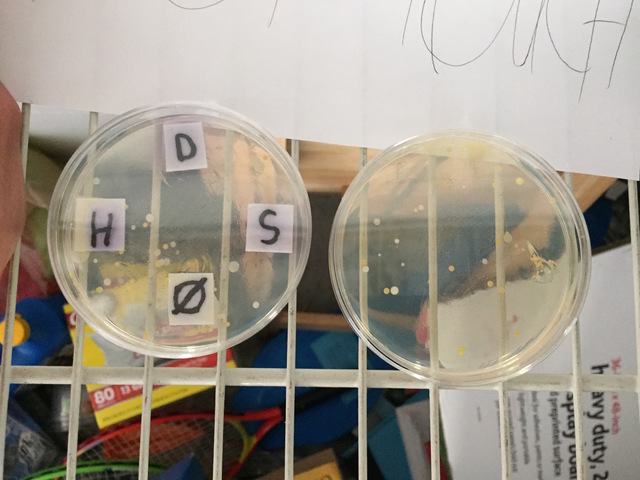
Petri Dish Day 6
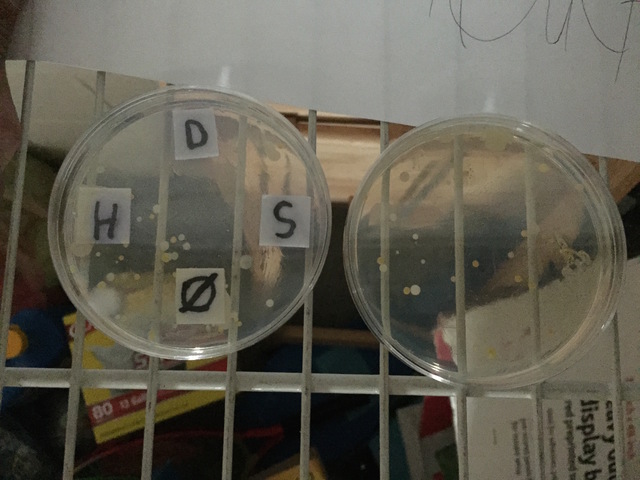
Petri Dish Day 7

-
This picture was immedietly after the experiment was steup.
-
This picture was taken 1 day after the start of the experiment. No bacteria colonies have become visible yet.
-
Day 3 of bacteria growth. There is still no sign of bacteria colonies growing just yet.
-
On day 3 bacteria colonies have grown! The bacteria had grown in the areas with hand sanitizer as well as the area with no soap. The hand sanitizer has 12 colonies while the one with nothing has 16 colonies. The control dish has 18 bacterial colonies total
-
More bacteria has grown on this day. The hand sanitizer area has 12 colonies of bacteria growing in it. The area with no types of soap or anything has 16 colonies growing in it. About halfway between dial and softsoap there are 3 colonies of bacteria growing. The control dish has a total of 27 bacteria colonies total.
-
In this picture bacter production has increased once again. The hand sanitizer are still has 12 bacteria colonies. The are with nothing now has 18 bacteria colonies. There is also one big colony halfway between soap and the area with nothing. The control dish has 29 bacteria colonies.
-
This day we can see color differences between bacteria colonies. The colonies can be seen as white, yellow and orange. The hand sanitizer area still has 12 colonies of bacteria. The area with nothing has 19 colonies. There are still 3 colonies in between Dial and Softsoap. There is also still one between Softsoap and the nothing area. The control dish has 30 colonies of bacteria
-
This is the last day of recording data for the experiment. The hand sanitizer area has 13 bacteria colonies. The area with nothing has 19 colonies. There is still one colony between Softsoap and the area with nothing. There are also still 3 colonies between Dial and Softsoap. The control dish still has 30 colonies of bacteria.
Want to make a timeline like this?
Use Timetoast to turn dates, events, milestones, and phases into a clear visual timeline you can build and share. Timetoast is a timeline maker for work, school, research, and stories.